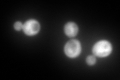
YDR502C
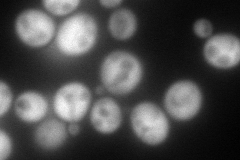
YDR502C
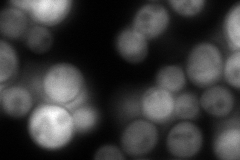
YDR502C
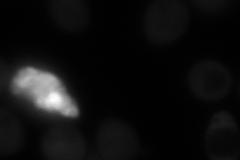
YDR502C
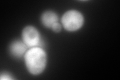
YDR502C

View description
S-adenosylmethionine synthetase, catalyzes transfer of the adenosyl group of ATP to the sulfur atom of methionine; one of two differentially regulated isozymes (Sam1p and Sam2p)
Localization:
Intensity:
Fold change:
Significance:
-
C’ GFP library in SD
cytosol599.86 -
N' NOP1pr-GFP in SD
cytosol256.073 -
N' TEF2pr-mCherry in SD

cytosol302.346 -
N' NATIVEpr-GFP in SD
cytosol275.591 -
N' TEF2pr-VC and Cyto-VN in SD
cytosol84.365 -
C’ GFP library in SD+DTT
cytosol447.990.74No -
C’ GFP library in SD+H2O2

cytosol738.91.23No -
C’ GFP library in Starvation Media

cytosol1738.672.89Yes -
C’ GFP library on the background of Pup2-DaMP

cytosol -
C’ GFP library on the background of CCT mutant

cytosol574.3620.95748No
